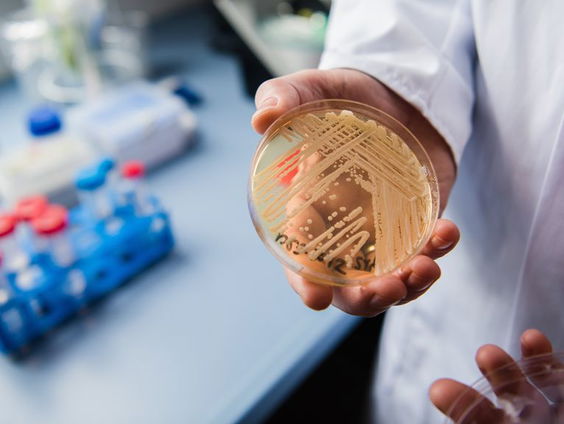
Waarom weten we zo weinig over schimmels?

Uitzending gemist

Nieuws en Co
- Gids
- Nieuws en Co
Gepresenteerd door: Fleur Wallenburg
In Nieuws en Co word je aan het eind van de middag bijgepraat over het nieuws van de dag. We brengen de grote nieuwsverhalen én de verdieping daarbij. Fleur Wallenburg presenteert elke maandag tot en met donderdag, Dieuwke Teertstra hoor je op vrijdag. Nieuws en Co is een samenwerking tussen de NOS en NTR en is elke werkdag van 17.00 uur tot 18.30 uur te horen op NPO Radio 1.